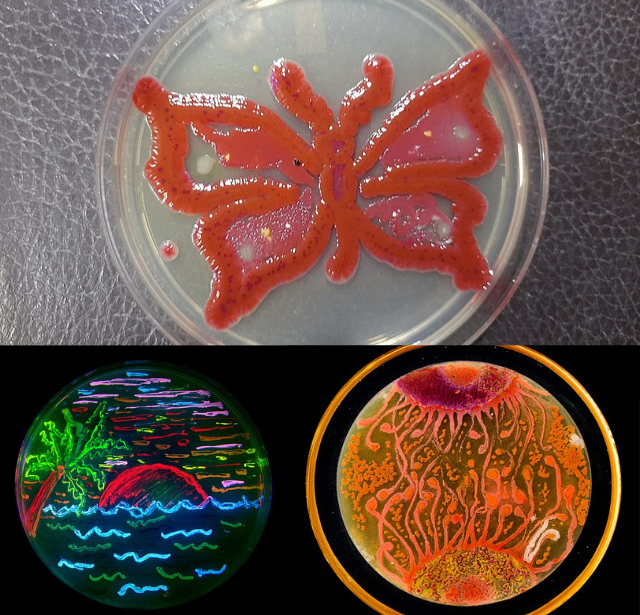
Microbes in art - Different artworks submitted in different competition
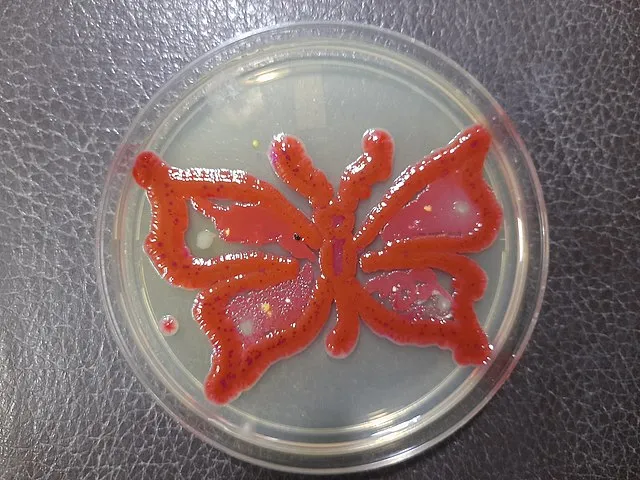
Microbes in art - Microbial Art: Using living microbes this type of butterfly art prepared

Art comes in different forms. Art refers to things that stimulate a person’s thoughts, ideas, senses, or beliefs through other senses. So, imagine using microbes and their characteristics in creating art.
Microbes in art mean using or integrating microorganisms like bacteria, algae, and fungi into artistic practices. This sector combines the different fields of microbiology and art.
Every year different microbiological communities organize agar art competitions with different themes. For example, the American Society of Microbiology (ASM) is organizing an ASM agar art competition in 2023 with the theme of microbiology in space.
The Concept of Microbes in Art
Microbes in art help explore the aesthetic, scientific, and conceptual aspects of microscopic life forms. There are different microbial art forms like art in agar medium, creating living sculptures, and paintings that rely on the growth and behavior of bacteria or fungi. The pigments produced by microbes are useful in making bio-dyes and bio-inks for artistic purposes.
The most common and explored form of microbes in art is agar art, where microbiologists grow bacteria or fungi using their artistic skills. Microbiological artists study the growth pattern of microbes, how these interact in their environment, and change their growth patterns.
The artists may manipulate environmental conditions like humidity, nutrient availability, and temperatures to guide microbial artworks’ growth and visual outcome. The evolving nature of microbial art forms makes them a temporal element of the art form.
Incorporating microbes in art has opened up exciting collaborations between artists and scientists/researchers. The partnership involves accessing scientific equipment, expertise, and cultures of microbes. Along with access to these fields, there will be increase in discussions around the ethical and safety considerations of working with living organisms.
While making the microbial art, themes have different concepts, like the relationship between humans and microbes, highlighting the role of microbes in our body, the environment, and ecosystems. Others indulge in the invisible world of microbes, revealing microbial life’s complexity and beauty. In addition, microbial art addresses broader ecological, ethical, and social issues related to microbiology, like antimicrobial resistance or the impact of human activities on microbial communities. Â
Microbes in art have opened up a unique perspective on the intersection of science and creativity. This concept has also developed many movements like DIYbio and bio art, which allow enthusiasts and artists to experiment with microbiology and genetic engineering in non-institutional settings. These movements help promote public engagement with science under ethical boundaries. Â
Agar Art Competition
The participants then use bacteria or fungi’s growth patterns and colors and produce visually captivating artworks in the agar. There are things to consider before participating in the agar art competition.
Some of the things to consider before entering the competition are the concept, procedure, themes, proper photographing, using the right microbes, understanding the criteria for judging, and safety measures.

Concept and process
The idea of agar art combines microbiology and art; using living microbes is a priority. The method includes preparing agar plates in Petri dishes after proper sterilization. Once the agar solidifies, participant inoculate the selected microorganisms in the medium in specific patterns and shapes using sterilized tools. The microbes grow and produce colorful colonies, which are the base for the artwork.
Participation and themes
Participation is open to diverse backgrounds, from scientists to artists, students, and enthusiasts. Anyone can compete in the contest, with specific themes in different years. The theme can range from pop culture to social issues and nature. Creativity is encouraged by incorporating various microbial species and techniques for their designs.
Selection of microbes
Microorganisms used can be chosen by free will by the competitors. The choice must include ethical considerations, non-pathogenic bacteria, and fungi that display vibrant colors during growth. The microbial specimens commonly used are Serratia marcescens, which produces red pigment, Pseudomonas aeruginosa, which has a greenish-blue tint; Penicillium and Aspergillus are used for creating unique patterns and textures.
Understanding the judging criteria
Different competitions have different criteria the participants are judged on. Some will value your artistic merit and creativity. Others may appreciate the technical skill, microbial growth patterns, color combinations, and overall visual impact. The competitors may also require to add descriptions about the art or inspiration behind the art and the microbial species used.
Preventive measures
Participants should know the safety guidelines when working with microorganisms. They must adequately sterilize the equipment before and after use. They must use aseptic practices to prevent contamination or the spread of potentially harmful organisms. The disposal of the artwork should also be in a safe manner. So, following provided guidelines about preventive measures before, during, and after creating the artwork is very important.

Photographing techniques
Although the artwork may be superb, the photographing method can make or break the chance of winning the competition. Clicking pictures under natural light instead of bright overhead lights is suggested. Natural light will prevent shadowing from phones and cameras. The background must be neutral. If the organisms were non-pathogenic and under a controlled and safe environment, the top lid might be removed to prevent the glaring effect.
References and further reading
- ASM agar art contest: Overview. (2023).https://asm.org/Events/ASM-Agar-Art-Contest/Home**
- Tsang, J. (2021, May 3). This gorgeous art was made with a surprising substance: Live bacteria. Science. https://www.nationalgeographic.com/science/article/agar-art-contest-winners-create-gorgeous-art-from-live-bacteria Â
- Sulaiman, Suraya & Wi, Wan & Othman, Mohd & Najib, Mohd. (2022). Microbial Art: An Integration of Art and Microorganisms.
- Hunt, G., & Lontok, K. (2022, August 19). Top 5 agar art tips. ASM.org. https://asm.org/Articles/2019/September/Top-5-Agar-Art-Tips